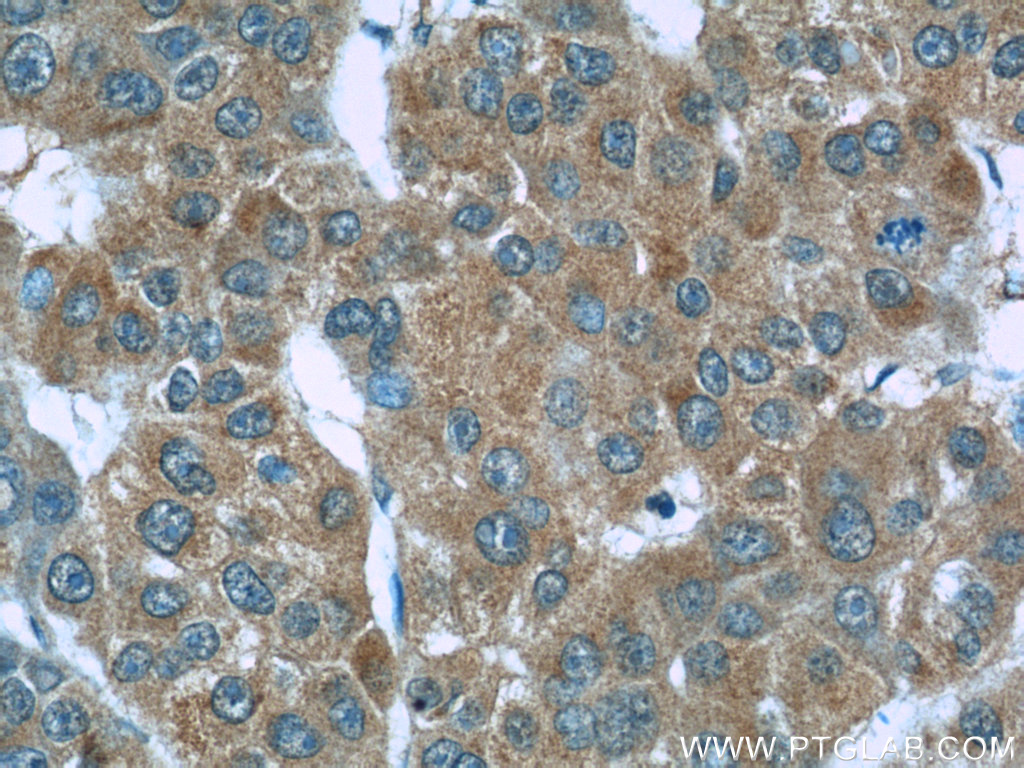

验证数据展示
产品信息
66098-1-PBS targets S100A6 in WB, IHC, IF/ICC, Indirect ELISA applications and shows reactivity with human samples.
| 经测试应用 | WB, IHC, IF/ICC, Indirect ELISA Application Description |
| 经测试反应性 | human |
| 免疫原 |
CatNo: Ag17606 Product name: Recombinant human S100A6 protein Source: e coli.-derived, PET28a Tag: 6*His Domain: 1-90 aa of BC001431 Sequence: MACPLDQAIGLLVAIFHKYSGREGDKHTLSKKELKELIQKELTIGSKLQDAEIARLMEDLDRNKDQEVNFQEYVTFLGALALIYNEALKG 种属同源性预测 |
| 宿主/亚型 | Mouse / IgG1 |
| 抗体类别 | Monoclonal |
| 产品类型 | Antibody |
| 全称 | S100 calcium binding protein A6 |
| 别名 | 3D11C8, CABP, CACY, Calcyclin, Growth factor-inducible protein 2A9 |
| 计算分子量 | 10 kDa |
| 观测分子量 | 10 kDa |
| GenBank蛋白编号 | BC001431 |
| 基因名称 | S100A6 |
| Gene ID (NCBI) | 6277 |
| RRID | AB_2881497 |
| 偶联类型 | Unconjugated |
| 形式 | Liquid |
| 纯化方式 | Protein A purification |
| UNIPROT ID | P06703 |
| 储存缓冲液 | PBS only, pH 7.3. |
| 储存条件 | Store at -80°C. The product is shipped with ice packs. Upon receipt, store it immediately at -80°C |
背景介绍
S100A6 is also named as calcyclin, prolactin receptor-associated protein (PRA), growth factor-inducible protein 2A9 ir MLN4. It belongs to S100 family of low molecular weight, acidic, calcium-binding proteins which contain two EF-hand calcium binding sites. S100A6 may function as a calcium sensor to activate several processes in the calcium signal transduction pathway of cell growth, proliferation, secretion and exocytosis. Although S100A6 is a cytoplasmic protein, it can be located in the nuclear and cytoplasmic membranes in the presence of Ca2+ (PMID: 37670392).